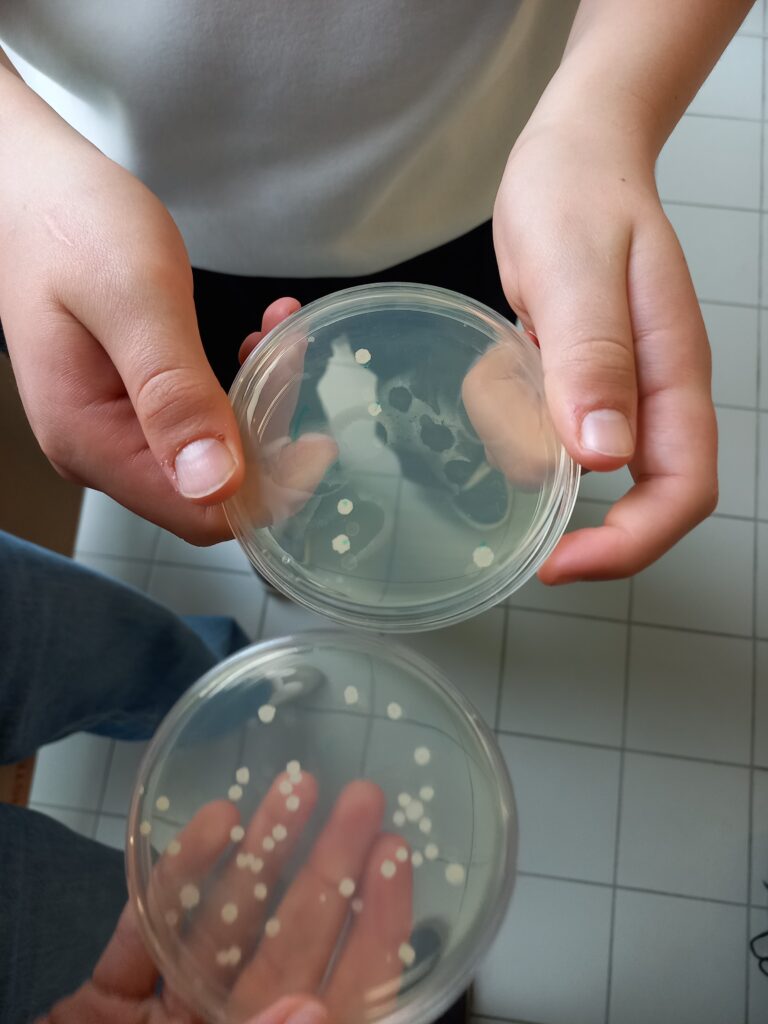

Vendredi 13 Mars, 13 élèves de 4ème se sont rendus au lycée professionnel Martin Nadaud de Bellac, pour la journée de l’éco-construction. Ils y retourneront les Jeudi 19 Mars et Jeudi 2 Avril pour des journées d’immersion, où ils découvriront les métiers du bâtiment : peinture, maçonnerie, charpente, métiers du froid, etc.
Ce même jour, 12 élèves de 3ème, accompagnés par Mme Degot, se sont rendus à Limoges à l’école d’ingénieur ENSIL-ENSCI. Au programme :
- Visite de la Maison de l’énergie : ateliers sur l’effet de serre, sur les barrages hydrauliques, visite de l’exposition temporaire « Quand l’Art’alerte ».
- Visites d’entreprises par petits groupes : Enedis, Axione, Laboratoire de recherche X’Lim, etc.
- Ateliers de découverte de l’ENSIL-ENSCI : TP de microbiologie, construction de drones, programmation informatique, atelier céramique, etc.
Après une journée de dur labeur, les élèves ont pu profiter du match de handball LH – Istres au Palais des Sports de Beaublanc à Limoges.

Commentaires récents